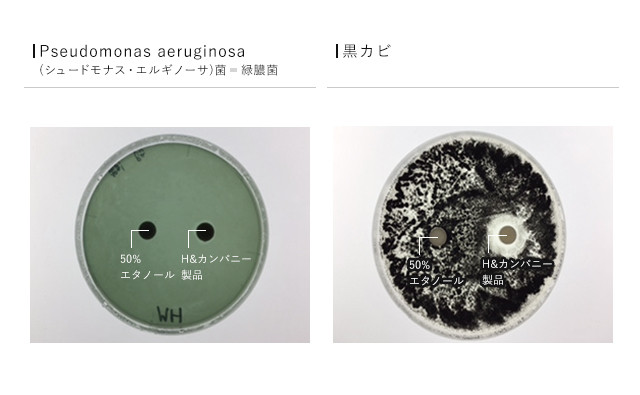

プロジェクト実行者
ストーリー

全成分植物由来、香料成分は天然精油100%のロールオンフレグランス「amurôme®」(アミュローム)ラインの新たな展開「Crisp Morning」。
今まで「ありそうでなかった」、どんなシーンでも気軽に使え、誰にでも好印象を与えるボタニカルな香りを爽やかに漂わせるためのエッセンスがつまった、特に大人の男性に「相棒」としていただきたい特別仕様品です。 そんな「Crisp Morning」の様々な魅力を皆様にお伝えしたいと思います。


H&カンパニーのブランド「amurôme®」(アミュローム)は、全て香料成分は植物から集めた天然100%エッセンス「精油(エッセンシャルオイル)」及びエキスを使用し、溶媒も植物由来のものを採用しています。
動物から抽出した香料成分や人工香料は一切使用していませんので、動物を傷つけたりすることもなく、また香りが不自然にしつこく残り続けることもありません。
また、「精油(エッセンシャルオイル)」は、古来より薬草などとして使われてきた植物を原材料としており、その複雑な植物ごとの香りの特徴はもちろんのこと、それらが持つパワーとバランスにも着目しながら、精油のプロ・アロマセラピストが絶妙なブレンディングを行っています。
この「amurôme®」(アミュローム)のコンセプトだからこそ、今までありそうでなかった、「爽やかな自然な香りで自分も良い気分になるだけでなく、周囲にも好印象を与えて清潔感をアップ」するというメンズフレグランスを完成させました。
また、リラックスしたい時、気分転換したいときにも大変おすすめです。


「香り」は、脳の中でも人の感情や行動、記憶を担当する大脳辺縁系という部分に直接働きかける唯一の感覚です。
わずか0.15 秒程度で脳に届く「香り」という刺激は、人の第一印象において「視覚」に次いで相手に「好き」を印象付けると共に、逆に「この人イヤ」と思わせるトップ(特に女性の感覚では圧倒的)の要素なのです。
「好印象な香り」を効果的に漂わせるための香水
これまでのメンズフレグランスは、ムスクなどの動物性香料の香りをベースにした「男性的」を意識、アピールするための香調のものが多く、特に使う方自身の元々の香りによっては、ともすればくどい印象となり、「印象アップのため」「エチケットのため」だったのが、全くの逆効果となってしまうことも多くありました。
そんなこれまでのメンズフレグランスの印象を覆すのが、今回皆様にご紹介する
H&カンパニーの「amurôme®」(アミュローム)ブランドから誕生するロールオンフレグランス「Crisp Morning」。
「Crisp Morning」は爽やかな朝、を意味します。
パリッとした朝の空気のように、アイロンがきいたシャツをシャキッと身に着けるような、そんな爽やかなイメージの香り。
「オンもオフも、ナチュラルで爽やか、魅力的な男性に寄り添う」ようなイメージで名づけました。

 (※印はオーガニック原料)
(※印はオーガニック原料)
【全体の香調】
レモン様を中心とした柑橘香とスパイス香からミントの爽快さが覗くトップノートから、微かにフローラルさを纏うウッディな香りへと移り変わる、すっきりとしたボタニカルな香り。
■シトロネラ ※
東南アジア、スリランカ、南米に生息するイネ科の植物。葉から抽出。
レモンのような爽やかさにグリーンさを併せ持つ香り。 抗菌、抗ウイルス、抗真菌(カビ)、免疫向上などの作用があるとされ、更にアメリカ農務省(USDA)が開発した抗酸化指数(ORAC)調査において、72種類の精油中第3位の抗酸化力を持っています。 また、疲労感や不安感を和らげ、抗うつ効果もあるとされます。
■和ハッカ ※
日本在来のハッカ属の植物。北海道が産地として有名。全草から抽出。
ミント類の中でもスーッとする成分「l-メントール」を多く含むため、非常に爽快感があります。 殺菌、抗ウイルス、抗真菌(カビ)、鎮痛などの作用があるとされ、ストレスを癒し気分をリフレッシュしてくれます。
■クロモジ
日本の本州、四国、九州に分布するクスノキ科の木。枝葉から抽出。
古くから茶席などで用いる高級爪楊枝に加工されており、精油としては採油率が非常に低く、貴重で大変高価。
樹木から採れる精油ですが、リナロールというラベンダーやベルガモット(アールグレイ紅茶の香りづけに使う柑橘類)にも含まれる成分を多く含み、ウッディながら華やかさもある香り。
抗ウイルス、抗菌、抗酸化、免疫賦活などの作用と共に、リラックス効果が非常に高いとされています。
■トドマツ (FSC認証林原料)
北海道から千島列島南部、サハリン、カムチャツカ半島に生息するモミの木の仲間。枝葉から抽出。
深い森を感じさせながらも優しく沁みとおるような香り。
まさに森林浴をしているようなリラックス効果と共に、各種悪臭への消臭効果、大気汚染の原因物質の大きな要素である「二酸化窒素(NO2)」等無害化による空気中低減効果、抗酸化機能などが研究によってわかっています。
■スイートオレンジ ※
ブラジル、アメリカ、メキシコ等で産出される柑橘類。果皮から抽出。
馴染みのあるいわゆる「オレンジ」の香りで、温かさを感じさせてくれます。
抗菌、抗ウイルス、鎮静ほか様々な作用を持ち、気持ちを明るく高揚させ、不安な気持ちや緊張感を和らげるとされています。
■プチグレン ※
スペイン、イタリア、チュニジア等で産出される「ビターオレンジ」の枝葉から抽出。
柑橘類の「苦味」を感じさせる心落ち着く香り。
抗菌、抗ウイルス、抗真菌(カビ)といった作用のほか、鎮静、抗痙攣などの特徴も併せ持ち、責任やプレッシャーに押し潰されそうな時などに気持ちを支え、穏やかに。
■タイムチモール ※
スペイン、フランス等で主に採れる料理にもよく使われるハーブ「タイム」の全草から抽出。
独特のスパイシーさが力強さを感じさせる香り。やる気を高め、活力向上に働くとされています。
タイム精油の中でも、「チモール」という精油成分最大ともされる抗菌、抗ウイルス、抗真菌(カビ)の性質及び抗酸化機能を持つ成分を多く含むタイプのものを採用しています。
■クローブバット ※
マダガスカル、インド、インドネシア等で主に採れる、スパイスとしても著名な「クローブ」のつぼみから抽出。
独特の芳香を持ち、「百里香」とも言われるほど強く香る事で古くから知られました。
精神的、肉体的に弱っているように感じるときに心身を強化し、自信を持たせてくれるとされています。
殺菌力も高く、また抗酸化力もアメリカ農務省(USDA)の抗酸化指数(ORAC)調査において、72種類の精油中第1位です。
■さとうきび抽出物
沖縄産のさとうきび汁から抽出されたもの。 さとうきびの様々な成分を含む黒砂糖には、肉や魚の臭みを抑える性質があることに着目し、開発されました。
これに含まれるさとうきびポリフェノールが、悪臭物質に吸着・接着して悪臭としての揮発性(におい)の喪失、酸素や紫外線、活性酸素による酸化防止に作用します。
(上記は原材料植物の一般的な性質の一部を述べたもので、化粧品の効能を示したものではありません。)


「Crisp Morning」を開発するにあたって考えたのが、従来のように「臭い」を覆い隠す目的のフレグランスではなく、精油ほかナチュラルなボタニカル素材のパワーで「臭い」に働きかけることで、原材料そのものの魅力的な「匂い」を楽しめるものにしたい、ということ。
商品開発にあたっても、香りの調和とそれらを両立させるために何度も試作を重ね、先にご紹介したような素材を厳選いたしました。
一般的に不快とされる「体臭」は、皮膚常在菌の繁殖から代謝が起こり、特定の物質へと変化することから発生します。
今回「Crisp Morning」について検査したところ、様々な菌類に対して、有意な抗菌活性を発揮することが確認できました。
実験環境:各培地に105cfu/ml の菌液100ml をまき、ディスクに50%エタノールとH&カンパニー製品をそれぞれ40μl、染み込ませた。
下記全てにおいて「Crisp Morning」周辺に阻止円(菌の発育がみられないエリア)が確認できます。
また、原料のさとうきび抽出物に含有されるさとうきびポリフェノールの効果においても、消臭効果が期待されます。
また、原料のさとうきび抽出物に含有されるさとうきびポリフェノールの効果においても、消臭効果が期待されます。




一般的に香水の形態で多いのがスプレータイプ。香りを広範囲に拡散できますが、量のコントロールが難しかったり、拡散しすぎて服にも多量に付着したり、周囲にも迷惑になってしまうことも。
そんなお悩みを「amurôme®」(アミュローム)ではロールオンタイプで解決。
香らせたい場所、においの気になる場所など、「ココ」というところだけにピンポイントで確実に塗ることができ、しかもごく少量で必要十分な効果が期待できます。
そして「amurôme®」(アミュローム)は、いつでもお守りのように、相棒のように持ち歩いてほしい、という願いから、専用ポーチをお付けしています。これで男性の方でもさり気なく持ち歩いて、いつも「香りを味方に」していただけます。

このような箱に入った状態でお届けします。

携帯用のポーチが同梱されていますので、中に入れて持ち歩いてください。
使うときは、ポーチから取り出して本体キャップを開けて 本体先のロール部をお肌の塗りたい場所に軽く押し当てるようにして、ごく少量塗布してください。

又は指先にごく少量つけて、目的の場所に塗布していただいても。
「Crisp Morning」おススメの塗り方
襟足から首の後ろ付近に

耳の後ろに

手首に


【朝 7:15 a.m.】

これから会社に出勤。
服装だけじゃなくて、「匂い」も大切なエチケット。
最後の仕上げに首の後ろと耳の後ろにひと塗り。
このあたりは鼻より後ろだから、特に自分のにおいには気づきにくい。
気をつけなきゃな、と思う。
【昼 12:55 p.m.】 
午前の仕事、そして上司との昼食が終わってほっと一息。 昼前の取引先との条件交渉は、結構気を使って疲れた。
午後から新規のアポイント先への外出があるし、「Crisp Morning」でリフレッシュして気合入れる。
【夜 6:20 p.m.】

退社後、これから取引先と会食。 今日は一日、社内でも社外でもずいぶん動き回ったから、汗もちょっとかいたかな。 もう一度首、耳の後ろに「Crisp Morning」つけてケアしておこう。
【休日の朝】

今日は朝からちょっと遠出。
久々にリフレッシュできそうだ。
一日中目一杯楽しむ予定だから「Crisp Morning」も忘れずに。
これさえあれば、誰かの近くでも、ちょっと汗をかいても本当に安心だ。

発売にあたり、モニターでお試しいただいた方々のご感想です。
【30代後半 男性】
普段こういったものは使っていなかったけど、すっきりとしていい匂いで気に入りました。
会社で何人かの女性の同僚に「いい匂い!」と言われましたよ。
【40代前半 男性】
最近、幼稚園児の娘が「なんだかパパからにおいがするからやだ」と自分の近くに来てくれなかったんですが、これを使ってみたら「パパ、いいにおーい」といって、以前のように近くに来て遊ぶように。
自分ではよくわかっていなかったんですが、ほんの少し使うだけでずいぶん変わるものなんですね。
【30代後半 女性】
夫に使ってもらいました。出勤前に、私が首の後ろと耳の後ろに塗ってあげました。
最近少し夫の臭いが気になっていたのですが、ちょっと塗るだけで気にならなくなりましたし、いい香りが夫からするのはやっぱり嬉しいですね。
私自身もつけてみましたが、女性でも楽しめる爽やかな香りだと思います。
パッケージも素敵。プレゼントするのにもとってもいいと思います。


「amurôme®」(アミュローム)は、弊社メンバーが15年以上前にセラピストとして仕事を始めたころ、「毎日のように悩まされている片頭痛に、アロマセラピーで何かできることはないか」とご相談いただき、ロールオンでの使用をご提案したことから始まりました。
その後徐々にブレンドを洗練させていき、株式会社H&カンパニー設立後に検討を加え、2016年2月に全成分植物由来、香料成分は天然100%のロールオンフレグランスとして商品化。
ブランド名を、「いつでもお守りのように香りを持ち歩いてほしい」との願いを込めて、近代アロマセラピーのふるさとフランスの言葉「amulette(アミュレット)」<お守り>と「arôme(アローム)」<香り>を掛け合わせて考案した「amurôme®」(アミュローム)とし、当製品の原点となったぼうっとした頭をスッキリさせる「Refresh Breeze(リフレッシュブリーズ)」、日々の気持ちの揺れを穏やかに癒す「Calm Song(カームソング)」の2ブレントを発売しました。
更に2017年7月には、「”3時のおやつ”の時の満ち足りた気持ち」をイメージした新ブレンド「Three O’clock」を発売。
そんな中、「amurôme®」(アミュローム)ご愛用の男性のお客様から
「男性向けに香りをブレンドしてほしい」 とご要望いただき、複数のお話を伺う中で、
「爽やかな好印象を与える香りで、かつ男性特有のにおいもケアできるもの」 というテーマがクローズアップされ、様々な試行錯誤の結果「amurôme®」(アミュローム)特別仕様品として完成したのが、今回ご紹介の「Crisp Morning」です。


製品仕様等
外装:135mm×85mm×50mm
本体:ガラス製ボトル
先端部:ステンレス製ロールオンボール
内容量:5.5ml
お届け予定:2017年9月以降順次発送予定

Q1. どのように使えばいいですか?
→A1. 上記の「使い方」をご参照ください。
Q2. 塗るときに注意することはありますか?
→A2. 強い直射日光が当たる所やお肌が傷ついている所などへの塗布は避け、少しずつご使用ください。
その他詳細は同梱の説明書をよく読んでご使用ください。
Q3. 使用期限はありますか?
→A3. 一般的にフレグランスで使用期限を設ける例はあまりないですが、「amurôme®」(アミュローム)は全て天然植物由来成分を使用しており、その香りがフレッシュなうちにお楽しみいただくため、開封後約3か月を目安にご使用いただくことをお勧めしております。


医学博士、薬剤師、セラピスト、講師など、様々なバックグラウンドを持つ3名の女性で2015年5月に設立。
アロマセラピー、ハーブ、漢方など植物素材の持つ力や各種療法を、単なるリラクゼーションや趣味にとどまらない、エビデンスや研究を元に積極的、戦略的に人々の健康や暮らしに取り入れていくことを目指し、主に医療機関や介護関連施設に向けて活用方法を提案する総合コンサルティングを行っています。
また、社会に広くアロマセラピー・ハーブ・漢方のチカラを、日本の伝統医療の思想を取り入れながら広めていくための「艸楽(そうらく)プロジェクト」、女性セラピストのネットワーク構築とスキルアップ、講師力向上を目指す「講座ラボ事業」などを行っています。
代表取締役社長 石川奈美

薬剤師、医学博士(名古屋市立大学大学院医学研究科 予防・社会医学専攻)
管理栄養士
藤田保健衛生大学看護専門学校、名古屋女子大学、名古屋文理大学、 名古屋栄養専門学校 講師
中医アロマセラピスト(東西中医学院)
JAA(日本アロマコーディネーター協会)認定 アロマインストラクター、AHR(アロマハンドリラックス)ライセンス
NARD JAPAN(ナードアロマテラピー協会)認定 アロマアドバイザー
JHTA(日本ハーブセラピスト協会) 認定 ハーブスペシャリスト
日本疫学会会員、日本栄養改善学会会員、日本アロマセラピー学会会員
より多くの男性に、天然の植物の香りで魅力的になっていただくために。
それによって、ご自身や周りの方々がよりハッピーな気持ちになるために。
皆様のお力をぜひお貸しください。
どうぞよろしくお願いします!
サポーターからの応援コメント
文章のトップに戻る
応援購入する
このプロジェクトはAll in型です。目標金額の達成に関わらず、プロジェクト終了日の2017年08月30日までに支払いを完了した時点で購入が成立します。
【Makuake先行割!15%OFF】無制限

5,508円(税込)
(更新日:2017年09月07日)
御礼メール&「amurome(アミュローム)」ロールオンフレグランス「Crisp Morning」1個
★ 予定希望小売価格:6,480円(税込)
「amurome(アミュローム)」専用携帯ポーチ付
「Crisp Morning」専用化粧箱入
☆ 国内配送料込み。
【Makuake先行割!18%OFF Specialセット】先着100名様

10,627円(税込)
(更新日:2017年09月07日)
御礼メール&「amurome(アミュローム)」ロールオンフレグランス「Crisp Morning」2個
★ 予定希望小売価格(2個):12,960円(税込)
「amurome(アミュローム)」専用携帯ポーチ付
「Crisp Morning」専用化粧箱入
☆ 国内配送料込み。
【Makuake先行&早割!30%OFF Specialセット】先着35名様

12,851円(税込)
(更新日:2017年09月07日)
御礼メール&「amurome(アミュローム)」ロールオンフレグランス「Crisp Morning」2個 +
「amurome(アミュローム)」「Refresh Breeze」or「Calm Song」or「Three O'clock」いずれか1個
★計 18,360円相当
「Crisp Morning」予定希望小売価格(2個):12,960円(税込)
「Refresh Breeze」or「Calm Song」or「Three O'clock」平均小売価格:5,400円(税込)
「amurome(アミュローム)」専用携帯ポーチ付
「Crisp Morning」は専用化粧箱入
☆ 国内配送料込み。
【Makuake先行割!20%OFF】無制限

15,551円(税込)
(更新日:2017年09月07日)
御礼メール&「amurome(アミュローム)」ロールオンフレグランス「Crisp Morning」3個
★ 予定希望小売価格:19,440円(税込)
「amurome(アミュローム)」専用携帯ポーチ付
「Crisp Morning」専用化粧箱入
☆ 国内配送料込み。
【Makuake先行割!35%OFF】無制限

42,120円(税込)
(更新日:2017年09月07日)
御礼メール&「amurome(アミュローム)」ロールオンフレグランス「Crisp Morning」10個
★ 予定希望小売価格:64,800円(税込)
「amurome(アミュローム)」専用携帯ポーチ付き
「Crisp Morning」専用化粧箱入り
☆ 国内配送料込み。
【Makuake先行&早割!23%OFF】先着65名様

4,981円(税込)
(更新日:2017年09月07日)
御礼メール&「amurome(アミュローム)」ロールオンフレグランス「Crisp Morning」1個
★ 予定希望小売価格:6,480円(税込)
「amurome(アミュローム)」専用携帯ポーチ付
「Crisp Morning」専用化粧箱入
☆ 国内配送料込み。
「Makuake(マクアケ)」は、実行者の想いを応援購入によって実現するアタラシイものやサービスのプラットフォームです。このページは、 プロダクトカテゴリの 「自然のチカラが男をクールにリフレッシュ。「Crisp Morning」」プロジェクト詳細ページです。
